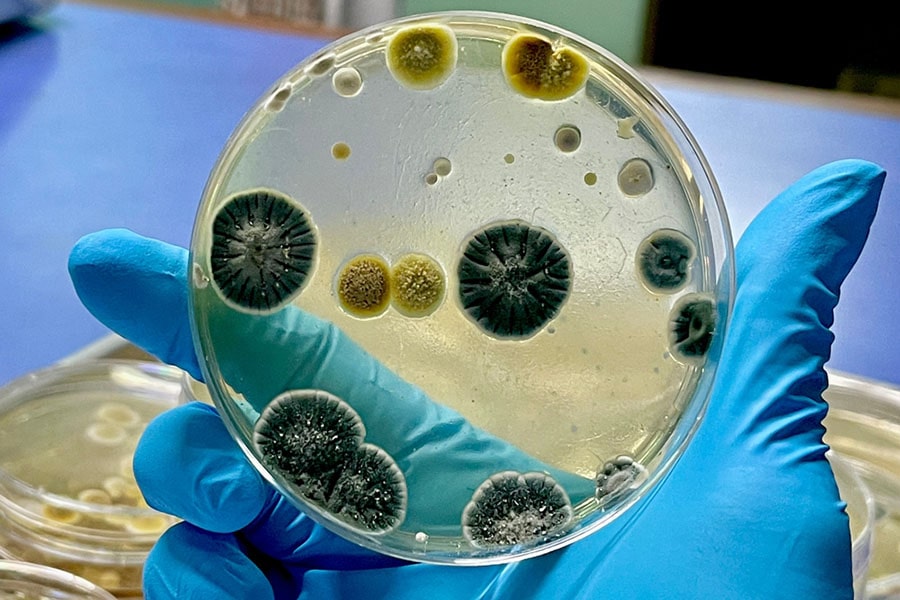

Solutions for Urinalysis Technologies
DIRUI Industrial Co. Ltd. is a leader in the technological development and production of leading-edge Diagnostic Equipment and Reagents. Dirui was founded in the early 90’s in China and is the pioneer of In-Vitro Diagnostics (IVD) in Mainland China. Dirui’s product portfolio represents complete Laboratory Solutions for the In-Vitro Diagnostic areas of Urinalysis. Dirui is well known for developing the game changing FUS-3000; which is the world’s only urine dry chemistry and urine flow cytometry sediment analyzer hybrid.


Early targeted antimicrobial therapy and source control during sepsis
Cube Dx was founded in 2015 and is located in St. Valentin (Austria). The company focuses on the development, production and distribution of multiplex tests for in-vitro diagnostics in clinical routine. Multiplex diagnostics allow for parallel identification of a variety of significant parameters (bacteria, fungi, resistance markers etc.) in a single test, requiring only a minimal amount of sample material.


The global burden of fungal infections 40 Years of Development
IMMY manufactures, markets, and distributes innovative lines of diagnostic tests and reagents for infectious diseases.
IMMY takes pride in producing reliable, accurate diagnostics, that bridge the gap between patients and the treatment they desperately need. IMMY goal is to make a monumental impact on the world by bringing crucial diagnostics closer to the patient. With products for cryptococcus, aspergillus, histoplasma, coccidioides, and blastomyces, along with mycobacteria specimen preparation reagents, IMMY is setting the standard with accurate and affordable diagnostics for infectious diseases.

Leader in microbiology innovation
QuantaMatrix was founded in 2010 as an in-vitro diagnostics company. It is a spin-off from Biophotonics and Nano Engineering Lab (BiNEL) at Seoul National University led by Dr. Sunghoon Kwon, professor of Electrical and Computer Engineering Department at Seoul National University. QuantaMatrix resolves antibiotics misuse issue and promote optimal antimicrobial prescription by providing direct Rapid Antimicrobial Susceptibility Testing (dRASTTM) for treating sepsis.
